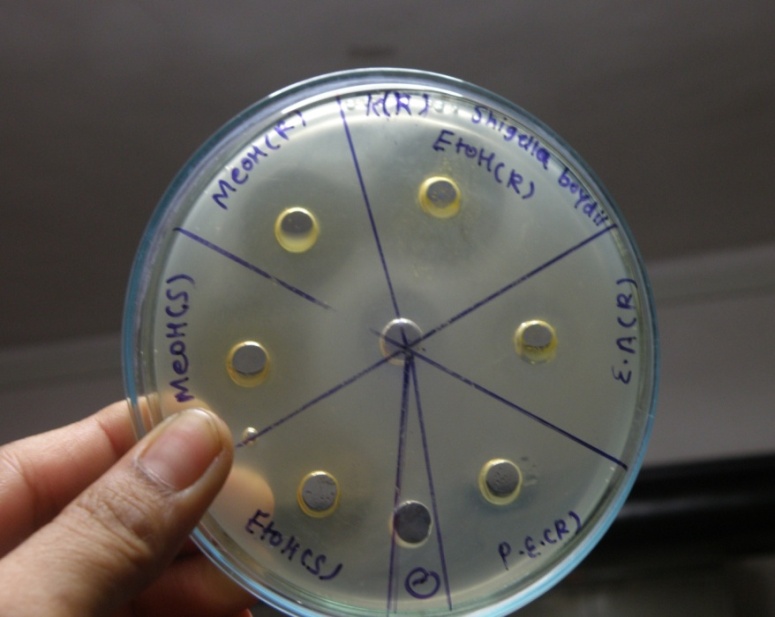

Guru Nanak Institute of Research and Development, Guru Nanak Khalsa College, Mumbai, Maharashtra, India
Email: hemangi131@gmail.com
Received: 18 Jul 2016, Revised and Accepted: 20 Aug 2016
ABSTRACT
Objective: Aim of the present study was to evaluate the antimicrobial activity of ripened and unripened fruits of Anthocephalus cadamba and Scirpus kysoor Roxb. tuber against food pathogens.
Methods: Different solvent extracts of Anthocephalus cadamba fruits and Scirpus kysoor Roxb. tubers were screened for its antimicrobial activity against Gram negative and Gram positive bacterial cultures by agar well diffusion method as well as by minimum inhibitory concentration (MIC) and minimum bactericidal concentration (MBC). MIC was carried out by broth microdilution method.
Results: All the plant materials exhibit antimicrobial activity. Among all plant materials, macerated ethyl acetate extract of Scirpus kysoor Roxb. tuber showed lowest MIC against Bacillus Cereus 0.312 mg/ml. In the case of ripened Anthocephalus cadamba fruits, macerated ethanol extract was found to be more potent whereas in the case of unripened Anthocephalus cadamba fruit macerated ethyl acetate extract was found to be more active on the basis of MIC.
Conclusion: This study revealed that all the plant materials possess significant antimicrobial activity against food pathogens hence may be used as a source of safe herbal antimicrobial agent.
Keywords: Anthocephalus cadamba, Scirpus kysoor Roxb., Antimicrobial activity, MIC, MBC
© 2016 The Authors. Published by Innovare Academic Sciences Pvt Ltd. This is an open access article under the CC BY license (http://creativecommonsorg/licenses/by/4.0/)
DOI: http://dx.doi.org/10.22159/ijcpr.2016v8i4.15269
INTRODUCTION
In recent years the main concern of regulatory and food industries is an increase in foodborne illness outbreaks by pathogens throughout the world. The other concerns are the increasing antibiotic resistance of some pathogens associated with foodborne illness and side effects of synthetic drugs. Hence it is essential to discover newer drugs with no or lesser microbial resistance [1].
Since ancient times plants have been utilized as therapeutic agents for various kinds of illness. Some natural substances originating from plants exhibit antibacterial properties [2]. Because of their lesser side effects and low resistance to pathogens, they are more popular than synthetic drugs. Because of such antibacterial properties, plant materials have been even used for prevention of food spoilage and preservation of foods from centuries. The antibacterial properties of plants are because of the secondary metabolites like alkaloids, terpenes, tannins, phenols, etc [3].
Anthocephalus cadamba and Scirpus kysoor Roxb. are two medicinally important plants containing various secondary metabolites. Anthocephalus cadamba belongs to family Rubiaceae. It’s common name is Kadam,in Marathi, it is known as Kadamba. Phytochemical investigation of different parts of Anthocephalus cadamba showed the presence of chemical constituents such as indole alkaloids, terpenoids, saponins, sapogenins, terpenes, steroids, fats, reducing sugar, glycosides and flavonoids [4]. Literature survey revealed that various parts of Anthocephalus cadamba possess antimicrobial activity [5-8]. The fruits showed significant antibacterial activity against some bacteria. But its antimicrobial activity against food-borne pathogens has been not yet reported.
Kaseru (Scirpus kysoor) belongs to family Cyperaceae. Its common name is Water chestnut and commonly it is found on the margins of ponds and swampy places throughout India. It is a good source of progesterone, starch and sugar. Various medicinal properties of Scirpus kysoor Roxb. has been described in Ayurveda [9, 10]. Antimicrobial property of Scirpus kysoor Roxb. has not been reported till date. Hence this study was carried out for exploring the antimicrobial potential of both these plants against food pathogens.
MATERIALS AND METHODS
All the chemicals reagents were procured from LobaChemie, India Pvt. Ltd. and microbiological media were obtained from Hi-media Laboratories.
Collection and authentication of the plant material
Anthocephalus cadamba fruits (ripened and unripened) were collected from Kaylan (Maharashtra) and Scirpus kysoor Roxb. tubers were collected from western ghats of Maharashtra. All these materials were authenticated from Agharkar Research Institute, Pune.
Extraction of plant material
Plant materials were shade dried, kept in an oven at 37 °C and finally ground to fine powder. Fine powder of Scirpus kysoor Roxb. (sieved through sieve of mesh no.44) and coarse powder of Anthocephalus cadamba fruit was used for extraction. All the 3 materials were extracted by Kinetic Maceration method on a rotary shaker for 24 h using solvents of different polarities i.e. Methanol, Ethanol, Ethyl Acetate, Chloroform, pet ether and Hexane [10, 11].
On the basis of results of antimicrobial activity (Zone of Inhibition) shown by macerated extracts of above solvents, 2 solvents were chosen for soxhlet extraction [11, 12] for each material.
For Ripened Anthocephalus cadamba fruits Methanol and Ethyl acetate, for unripened Anthocephalus cadamba fruits Ethanol and Methanol and for Scirpus kysoor Roxb tubers. Ethyl acetate and pet ethers were chosen as solvents for soxhlet extraction.
Culture and maintenance of microorganisms
Staphylococcus aureus (S. aureus) ATCC 25922 and Bacillus cereus (B. cereus) ATCC 11778 were 2-gram positive bacteria and Escherichia coli (E. coli) ATCC8739, Salmonella abony (S. abony) ATCC 6017 and Shigella boydii (S. boydii) ATCC 8700 were 3-gram negative bacteria used for this assay. All these bacterial cultures were obtained from Guru Nanak Institute of Research and Development (GNIRD) and Microbiology Department of G. N. Khalsa College, Matunga. All the bacterial cultures were maintained on nutrient agar medium at 4 °C till further use.
Preparation of inoculum
A single colony was transferred in sterile 50 ml of nutrient broth and incubated at 37 °C for 24 h. The concentration of bacterial cells was optimized to 0.5 McFarland standard (that corresponds to 1.5X 108 CFU/ml) at 620 nm for agar well diffusion assay.
Antimicrobial bioassay
Antimicrobial activity of all the materials was primarily evaluated by agar well diffusion method and further quantification was done by Minimum Inhibitory concentration (MIC) and Minimum Bactericidal Concentration (MBC) against the selected 5 food pathogens.
Agar well diffusion method
Agar well diffusion method was carried out as per guidelines provided by CLSI [13].
One ml of inoculum prepared was mixed thoroughly into 20 ml of sterile nutrient agar and poured into Petri plate of 9 cm diameter. After solidification of agar, wells were made by using 8 mm of cork borer. Fifty μl of respective plant extracts were added in respective wells. Plates were incubated at 37 °C for 24 h and zone of inhibition was measured in mm. Dimethyl Sulphoxide (DMSO) was used as negative control. Ciprofloxacin (5 ppm) was used as positive control [7, 14].
All experiments were repeated three times independently, and the mean and standard deviation of the diameter of inhibition zones were calculated. Values obtained were expressed as mean±SD.
Determination of minimum inhibitory concentration (MIC)
The minimum inhibitory concentration (MIC) is defined as the lowest concentration of the antimicrobial agent that will inhibit the visible growth of a microorganism after overnight incubation [15, 16].
Two-fold microdilution broth method was used to determinate the MIC value [17].
A stock solution of 4 most active extracts of both the Anthocephalus cadamba fruits was serially diluted in 96-wells microtiter plate with Nutrient broth to obtain a concentration of 25, 12.5, 6.25,3.12, 1.56, 0.78 mg/ml and that of Scirpus kysoor Roxb. tuber from10.0, 5.0, 2.5, 1.25, 0.625, 0.312 mg/ml. A standardized inoculum for each bacterial strain was prepared so as to give an inoculum size of approximately 5 x 105 CFU/ml in each well. Positive control well contained inoculated growth medium without test samples. The negative control well included uninoculated medium and DMSO. .Microtiter plates were then kept at 37 °C for an overnight incubation. The MICs of each extract were determined after incubation following the addition of 40 μl p-iodonitrotetrazolium salt(INT dye) and incubation at room temperature for 30 min. Viable bacteria reduced this yellow dye to pink. The MIC of each sample was defined as its lowest concentration that prevented this change and then resulted in the complete inhibition of microbial growth [18, 19].
Determination of minimum bactericidal concentration (MBC)
Bactericidal Concentration (MBC) was determined by streaking samples from the wells with concentrations of MIC and above the MIC on new plates of Nutrient Agar. The MBC was considered as the lowest concentration of the extract associated with no bacterial culture that is indicating 99.5% killing of the original inoculum [20].
RESULTS AND DISCUSSION
Antimicrobial bioassay
In the present investigation, the antimicrobial activity of different extracts of unripened and ripened Anthocephalus cadamba fruits and tuber of Scirpus Kysoor Roxb. were evaluated against five food pathogens. The antimicrobial activity was determined using agar well diffusion method and microdilution method summarized in table 3-8. The activity was quantitatively assessed on the basis of minimum inhibitory concentration (MIC), minimum bactericidal concentration (MBC) and ratio of MIC and MBC.
Measurement of antimicrobial activity using agar well diffusion method
The results of Agar Well Diffusion are summarized in table 1-3 which revealed that most of the plant extracts showed antibacterial activity at various degrees ranging from 10-24 mm (except n-hexane extract of the unripened Anthocephalus cadamba for E. coli).
Fig. 1: Ripened Anthocephalus cadamba fruit Zone of Inhibition against Shigella boydii, EtoH(R)-macerated ethanolic extract EtoH(s)-soxhlet ethanolic extract, MeoH(R)-macerated methanolic extract MeoH(s)-soxhlet methanolic extract, E. A.(R)-macerated ethyl acetate extract P. E.(R)-macerated pet ether extract, of ripened cadamba fruit ‘-’-negative control and center well–positive control
Table 1: Zone of inhibition of ripened Anthocephalus Cadamba (mm)
Ripened Anthocephalus Cadamba |
Staphylococcus aureus | Bacillus cereus | Escherichia coli | Salmonella abony | Shigella boydii |
| Methanol | 16.0±1.00 | 15.0±1.00 | 16.33±0.57 | 10.0±1.00 | 21.0±1.00 |
| Ethanol | 18.0±0.00 | 18.0±0.00 | 17.0±1.00 | 19.0±1.00 | 24.0±0.00 |
| Ethyl Acetate | 12.0±1.00 | 12.33±0.57 | 14.0±1.00 | 11.0±1.0 | 15.33±0.57 |
| Chloroform | 11.33±0.57 | 9.0±0.00 | 10.0±0.00 | 11.0±0.00 | 11.0±0.00 |
| Pet Ether | 11.0±1.0 | 12.33±0.57 | 11.0±0.00 | 11.0±0.00 | 14.33±0.57 |
| n-Hexane | 11.33±0.57 | 9.0±0.00 | 12.33±0.57 | 12.0±0.00 | 12.0±1.00 |
| Methanol (Soxhlet) | 13.0±1.0 | 14.0±1.00 | 11.0±0.00 | 11.0±1.00 | 17.0±1.00 |
| Ethanol (Soxhlet) | 15.33±0.57 | 15.0±1.00 | 12.33±0.57 | 12.0±1.00 | 17.33±0.57 |
| Ciprofloxacin | 19.0±1.00 | 20.0±1.00 | 28.0±1.00 | 22.0±1.00 | 15.0±1.00 |
| DMSO | - | - | - | - | - |
[‘-’–No zone of inhibition was observed]
Table 2: Zone of inhibition of unripened Anthocephalus cadamba(mm)
Unripened Anthocephalus Cadamba |
Staphylococcus aureus | Bacillus cereus | Escherichia coli | Salmonella abony | Shigella boydii |
| Methanol | 16.0±1.00 | 15.33±0.57 | 17.0±1.00 | 15.0±1.00 | 20.0±0.00 |
| Ethanol | 12. 33±0.57 | 14.0±1.00 | 11.0±1.00 | 12.0±1.00 | 18.0±1.00 |
| Ethyl Acetate | 14.33±0.57 | 14.0±1.00 | 15.0±1.00 | 13.33±0.57 | 18.0±1.00 |
| Chloroform | 11.33±0.57 | 12.0±0.00 | 13.33±0.57 | 11.33±0.57 | 11.0±0.00 |
| Pet Ether | 13.33±0.57 | 15.0±0.00 | 14.0±00 | 13.0±00 | 17.00±0.00 |
| n-Hexane | 11.0±1.00 | 12.00±0.00 | - | 12.00±1.0 | 11.33±0.57 |
| Methanol(Soxhlet) | 14.0±1.00 | 14.0±1.00 | 14.0±0.00 | 14.33±0.57 | 19.0±0.00 |
| Ethanol (Soxhlet) | 11.0±0.00 | 12.0±0.00 | 11. 33±0.57 | 12.33±0.57 | 17.0±1.00 |
| Ciprofloxacin | 19.0±1.00 | 20.0±1.00 | 30.0±1.00 | 22.0±1.00 | 15.0±1.00 |
| DMSO | - | - | - | - | - |
[‘-’–No zone of inhibition was observed]
Table 3: Zone of inhibition of Scirpus Kysoor Roxb. (mm)
| Scirpus kysoor Roxb. | Staphylococcus aureus | Bacillus Cereus | Escherichia Coli | Salmonellaabony | Shigella boydii |
| Methanol | 14.0±1.00 | 12.33±0.57 | 12.33±0.57 | 13.0±1.00 | 23.0±1.00 |
| Ethanol | 15.0±1.00 | 17.0±1.00 | 12.33±0.57 | 12.0±0.00 | 17.0±1.00 |
| Ethyl Acetate | 18.0±1.00 | 19.33±0.57 | 12.0±1.00 | 15.0±1.00 | 20.33±0.57 |
| Chloroform | 17.33±0.57 | 13.0±0.00 | 10.0±0.00 | 12.0±1.00 | 15.0±1.00 |
| Pet Ether | 19.33±0.57 | 19.33±0.57 | 13.0±1.00 | 14.0±0.00 | 20.33±0.57 |
| n-Hexane | 13.0±0.00 | 13.0±0.00 | 10.0±0.00 | 12.0±1.00 | 17.0±0.00 |
| Ethyl Acetate (Soxhlet) | 13.0±0.00 | 17.0±0.00 | 11.0±0.00 | 10.0±0.00 | 20.0±0.00 |
| Pet Ether(Soxhlet) | 17.33±0.57 | 17.0±0.00 | 12.0±0.00 | 11.2±0.00 | 17.33±0.57 |
| Ciprofloxacin | 17.0±1.00 | 19.0±1.00 | 30.0±1.00 | 23.0±0.00 | 15.0±0.00 |
| DMSO | - | - | - | - | - |
[‘-’–No zone of inhibition was observed]
Zone of inhibition<9 mm zone was considered as inactive; 9-12 mm as partially active; while 13-18 mm as active and>18 mm as very active [21]. According to this, most potent extracts of all plant materials were found to be either active or very active. Among the different solvent extracts studied, for ripened Anthocephalus cadamba fruits, macerated ethanol extract was found to be most potent extract against all the pathogens whereas for unripened fruits macerated methanol extract was found to be most potent. In the case of Scirpus kysoor Roxb. tuber macerated ethyl acetate and pet ether extracts were found to be most potent against all the pathogens. The maximum zone of inhibition was observed against S. boydii by macerated ethanol extract of ripened Anthocephalus cadamba fruit which was 24 mm. (shown in fig. 1). For S. Aureus highest antimicrobial activity exhibited by macerated pet ether extract of Scirpus kysoor Roxb. tuber (19 mm) followed by macerated ethanol extract (18 mm) of ripened Anthocephalus cadamba. For B. cereus macerated Pet ether and ethyl acetate extract of Scirpus kysoor Roxb. tuber (19 mm) followed by macerated ethanol extract (18 mm) of ripened Anthocephalus cadamba showed the highest activity. For E. coli, S. abony and S. boydii macerated ethanol extract of ripened Anthocephalus cadamba showed the highest activity (19, 17, 24 mm resp).
In general, ripened Anthocephalus cadamba showed greater antimicrobial activity as compared to unripened Anthocephalus cadamba.
The activity of potent extracts against all the pathogens (except E. coli) were found to be comparable with that of positive control.
Both soxhlets, as well as macerated extracts, showed antimicrobial activity but in most of the cases for same solvent and concentration, the zone of inhibition was found to be greater for macerated extracts.
Thus, all the plant extracts tested in the present study displayed broad spectrum antibacterial activity (that is against both gram positive and gram negative type of bacteria). However, differences observed between antibacterial activities of the extracts could be due to the differences in the chemical composition (i.e. different bioactive phytochemical groups/metabolites) of these extracts. Such secondary metabolites of plants have been reported to have many effects including antibacterial and antiviral properties [22, 23].
Determination of MIC and MBC
The antibacterial activity of the plant extracts is depicted in table 6-8. The results indicated that the plant extracts showed antibacterial activities at variable degrees against all the pathogens, with MIC values varying from 0.312 to 25.0 mg/ml. The lowest value of MIC was observed for macerated ethyl acetate extract of Scirpus kysoor Roxb. against B. cereus (0. 312 mg/ml). It is shown in fig. 2.

Fig. 2: MIC of plant materials against bacillus cereus, 1-4, 5-8, 9-12:-methanol,ethanol,ethyl acetate and pet ether extracts of unripened Anthocephalus cadamba, ripened Anthocephalus cadamba and Scirpus kysoor Roxb. Respectively
Table 4: MIC, MBC and MBC: MIC ratio of ripened Anthocephalus Cadamba
Ripened Cadamba |
Staphylococcus aureus |
Bacillus cereus |
Escherichia coli |
Salmonella abony |
Shigella boydii |
||||||||||
Solvent |
MIC (mg/ml) |
MBC |
MIC |
MBC |
MBC: |
MIC |
MBC |
MBC: |
MIC |
MBC |
MBC: |
MIC |
MBC |
MBC: |
|
Methanol |
6.25 |
6.25 |
1 |
6.25 |
25.0 |
4 |
12.5 |
25.0 |
2 |
12.5 |
12.5 |
1 |
6.25 |
25.0 |
4 |
Ethanol |
3.12 |
3.12 |
1 |
3.12 |
3.12 |
1 |
12.5 |
Above |
- |
12.5 |
Above |
- |
6.25 |
25.0 |
4 |
Ethyl Acetate |
6.25 |
6.25 |
1 |
12.5 |
12.5 |
1 |
25.0 |
25.0 |
1 |
12.5 |
Above |
- |
12.5 |
25.0 |
2 |
Pet Ether |
12.5 |
12.5 |
1 |
12.5 |
12.5 |
1 |
25.0 |
Above |
- |
NA |
NA |
NA |
12.5 |
25.0 |
2 |
n-Hexane |
NA |
NA |
NA |
NA |
NA |
NA |
NA |
NA |
NA |
12.5 |
12.5 |
1 |
NA |
NA |
NA |
Methanol (Soxhlet) |
12.5 |
12.5 |
1 |
6.25 |
6.25 |
1 |
12.5 |
Above |
- |
6.25 |
Above |
- |
6.25 |
- |
- |
Ethanol (Soxhlet) |
6.25 |
Above |
- |
3.12 |
12.5 |
4 |
12.5 |
Above |
- |
6.25 |
Above |
- |
6.25 |
- |
- |
[‘-’–not calculated, NA-not applicable]
Table 5: MIC, MBC and MBC: MIC ratio of Unripened Anthocephalus Cadamba
Unripened Cadamba |
Staphylococcus aureus |
Bacillus cereus |
Escherichia coli |
Salmonella abony |
Shigella boydii |
||||||||||
Solvent |
MIC |
MBC |
MBC: |
MIC |
MBC |
MBC: |
MIC |
MBC |
MBC: |
MIC |
MBC |
MBC: |
MIC |
MBC |
MBC: |
Methanol |
6.25 |
6.25 |
1 |
3.15 |
6.25 |
2 |
12.5 |
Above |
- |
12.5 |
Above |
- |
12.5 |
25.0 |
2 |
Ethanol |
6.25 |
12.5 |
2 |
6.25 |
6.25 |
1 |
12.5 |
Above |
- |
12.5 |
Above |
- |
12.5 |
25.0 |
2 |
Ethyl Acetate |
1.56 |
3.12 |
2 |
1.56 |
6.25 |
4 |
12.5 |
Above |
- |
12.5 |
Above |
- |
6.25 |
25.0 |
4 |
Pet Ether |
1.56 |
3.12 |
2 |
1.56 |
6.25 |
4 |
25.0 |
Above |
- |
12.5 |
Above |
- |
6.25 |
25.0 |
4 |
Methanol (Soxhlet) |
12.5 |
Above |
- |
6.25 |
Above |
- |
25.0 |
Above |
- |
12.5 |
Above |
- |
12.5 |
Above |
- |
Ethyl Acetate (Soxhlet) |
3.12 |
Above |
- |
3.12 |
Above |
- |
12.5 |
Above |
- |
12.5 |
Above |
- |
12.5 |
Above |
- |
[‘-’–not calculated, NA-not applicable]
Table 6: MIC, MBC and MBC: MIC ratio of Scirpus Kysoor Roxb
Scirpus Kysoor Roxb. |
Staphylococcus aureus |
Bacillus cerius |
Escherichia coli |
Salmonella abony |
Shigella boydii |
||||||||||
Solvent |
MIC |
MBC |
MBC: |
MIC |
MBC |
MBC: |
MIC |
MBC |
MBC: |
MIC |
MBC |
MBC: |
MIC |
MBC |
MBC: |
Methanol |
NA |
NA |
NA |
2.5 |
2.5 |
1 |
10.0 |
Above |
- |
5.0 |
10.0 |
2 |
5.0 |
10.0 |
2 |
Ethanol |
1.25 |
1.25 |
1 |
5.0 |
5.0 |
1 |
5.0 |
Above |
- |
5.0 |
10.0 |
2 |
5.0 |
10.0 |
2 |
Ethyl Acetate |
0.62 |
0.62 |
1 |
0.31 |
0.31 |
1 |
5.0 |
Above |
- |
5.0 |
Above |
- |
1.25 |
10.0 |
8 |
Chloroform |
0.62 |
2.5 |
4 |
NA |
NA |
NA |
NA |
NA |
NA |
NA |
NA |
NA |
NA |
NA |
NA |
Pet Ether |
1.25 |
1.25 |
1 |
1.25 |
5.0 |
4 |
10.0 |
Above |
- |
5.0 |
Above |
- |
5.0 |
10.0 |
2 |
EthylAcetate (Soxhlet) |
1.25 |
Above |
- |
1.25 |
2.50 |
2 |
5.0 |
Above |
- |
5.0 |
Above |
- |
2.5 |
Above |
- |
Pet Ether (Soxhlet) |
1.25 |
2.5 |
4 |
1.25 |
2.50 |
2 |
5.0 |
Above |
- |
2.5 |
Above |
- |
2.5 |
Above |
- |
[‘-’–not calculated, NA-not applicable]
In the case of Ripened Anthocephalus cadamba fruit, the lowest value of MIC was shown by macerated as well as soxhlet extract of ethanol against all the pathogens whereas in the case of unripened Anthocephalus cadamba; lowest MIC value was shown by macerated ethyl acetate and pet ether extracts. Macerated Ethyl acetate extract of Scirpus kysoor Roxb. exhibited lowest MIC values against all the pathogens. For S. Aureus,B. Cereus and S. boydii lowest MIC was shown by macerated Ethyl acetate extract of Scirpus kysoor Roxb. (0.625 mg/ml,0.312 mg/ml and 1.25 mg/ml respectively.) whereas For E. coli and S. abony also Lowest MIC was 5.0 mg/ml.)Thus, all these plant materials were found to be a more efficient antimicrobial agent against S. Aureus, B. Cereus and S. boydii than that of E. Coli and S. Abony on the basis of their MIC. Most of these extracts were found to be bactericidal (exception: macerated ethyl acetate extract of Scirpus kysoor Roxb. Against S. boydii) showing ratio of MBC: MIC</=4, against S. Aureus, B. Cereus and S. boydii whereas for rest 2 pathogens they were considered as bacteriostatic as MBC: MIC>4 [24].
Macerated extract showed lowest MIC as compared to soxhlet extracts of the same solvent of same concentration for S. Aureus,B. Cereus and S. boydii whereas it was found to be same for rest 2 pathogens with few exceptions. Both the soxhlet extracts of ripened Anthocephalus cadamba fruit and Scirpus kysoor Roxb. tuber were found to be bactericidal against B. Cereus. Also, soxhlet methanol extract of ripened Anthocephalus cadamba and soxhlet pet ether extract of Scirpus kysoor Roxb. were found to be bactericidal against S. Aureus. Rest soxhlet extracts were observed as bacteriostatic against remaining 3 pathogens.
The results for antibacterial activity of Anthocephalus cadamba were found to be comparable to those obtained by other authors. They reported that ethanolic extract of Anthocephalus cadamba showed significant antibacterial activity against Gram positive and Gram negative organisms. Alcoholic extract of fruits of Anthocephalus cadamba showed significant antibacterial activity against E. coli,, S. aureus with the zone of inhibition of 22-24 cm and low MIC value up to 1.00 mg/ml [5, 7]. The difference observed in some results may be due to the difference in the type of pathogenic strains used and method of extraction used in the present study.
From the zone of inhibition and MIC determination, it was observed that zones of inhibition in agar diffusion assay do not necessarily correlate to MIC values in the broth microdilution method,as already stated by Ncube et al.(2008) [25].
The results of the present work also bring additional data on the antibacterial activity of ripened and unripened Anthocephalus cadamba fruit, since we report for the first time its activity against B. cereus,S. abony and S. boydii. MBC is also reported first time for all the pathogens. Also, to best of our knowledge antimicrobial activity against all the pathogens for Scirpus kysoor Roxb. is described here for the first time.
CONCLUSION
From the present investigation, we can conclude that all the 3 plant materials contain potential antimicrobial components that may be useful for the development of pharmaceutical industries as a broad spectrum antibiotic against various diseases caused by food pathogens. The results of the study support the development of new antimicrobial drugs from both the plants. After this screening experiment, phytochemical studies and bioautographic studies of potent extracts will be necessary to isolate the active constituents and evaluate the antibacterial activities against selected food pathogens.
CONFLICT OF INTERESTS
Declare none
REFERENCES
How to cite this article